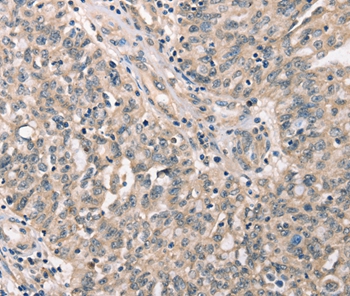
产品细节图片1

相关产品推荐更多 >
万千商家帮你免费找货
0 人在求购买到急需产品
- 详细信息
- 文献和实验
- 技术资料
- 免疫原:
Synthetic peptide corresponding to residues near the C terminal of human cyclin-dependent kinase 12
- 形态:
liquid
- 保存条件:
Store at -20˚C
- 克隆性:
Polyclonal
- 适应物种:
Human
- 保质期:
12 months
- 抗原来源:
Rabbit
- 供应商:
南京赛戈巍生物科技有限公司
- 宿主:
Rabbit
- 应用范围:
IHC
- 靶点:
Uniprot:Q9NYV4
- 抗体英文名:
CDK12 Antibody
- 规格:
50ul/100ul
配方:Rabbit IgG in pH7.3 PBS, 0.05% NaN3, 50% Glycerol.
应用详情:Immunohistochemistry: 1:25-1:100
图片:
Immunohistochemical analysis of paraffin-embedded Human ovarian cancer tissue using #37508 at dilution 1/30.
,

Immunohistochemical analysis of paraffin-embedded Human cervical cancer tissue using #37508 at dilution 1/30.
风险提示:丁香通仅作为第三方平台,为商家信息发布提供平台空间。用户咨询产品时请注意保护个人信息及财产安全,合理判断,谨慎选购商品,商家和用户对交易行为负责。对于医疗器械类产品,请先查证核实企业经营资质和医疗器械产品注册证情况。
文献和实验也可用辅酶型维生素B 12 、辅酶 B 12 等词来表示。是由 5- 脱氧腺苷基取代氰钴胺素( CN - B 12 )中与钴连接的 CN 基而生成的,所以亦称钴胺酰胺辅酶。其中大多数是核苷酸中的碱基为 5 , 6- 二甲(基)苯并咪唑的二甲(基)苯并咪唑钴酰胺辅酶( dimeth - ylbenzimidazole cobamide coenzyme )和钴胺素辅酶,但也有碱基为腺嘌呤或 5- 羟基苯并咪唑所置换的 B 12 辅酶。 B 12 辅酶是 H.Barker 等在研
A uniform procedure for the purification of CDK7/CycH/MAT1, CDK8/CycC and CDK9/CycT1
We have established a uniform procedure for the expression and purification of the cyclin-dependent kinases CDK7/CycH/MAT1, CDK8/CycC and CDK9/CycT1. We attach a His6 -tag to one of the subunits of each complex and then co-express
丁香园myl0605的观点:前几天为自己养的PC12是未分化还是分化型困扰,查了一些资料,现发上来希望能给有同样问题的战友有一点帮助!培养条件:PC12细胞培养于铺有鼠尾胶原的玻璃培养瓶中,置于CO2培养箱(37℃,95%空气5%CO2),培养基选用DMEM(pH7.4,高糖),加入10%灭活小牛血清及5%灭活马血清。分化前:PC12细胞在培养基中多呈圆形,直径15~20μm,也有椭圆或多角形的,扁平的细胞少见,倾向于聚集成小团簇状(A图)。分化后:加入NGF后的24h内细胞停止分裂,长出似
技术资料暂无技术资料 索取技术资料





![POLA1 Antibody[46645]](https://img1.dxycdn.com/p/s14/2025/0923/496/0462304380155040791.jpg!wh200)
![outer surface protein A Antibody[62125]](https://img1.dxycdn.com/p/s14/2025/0922/632/2321321568067599691.jpg!wh200)
![PCDH12 Polyclonal Antibody FITC Conjugated[C90623FITC]](https://img1.dxycdn.com/p/s14/2025/0922/498/0460884283108299691.jpg!wh200)

![LRP5 Conjugated Antibody[C36957]](https://img1.dxycdn.com/p/s14/2025/0923/278/4431488150116040791.jpg!wh200)

